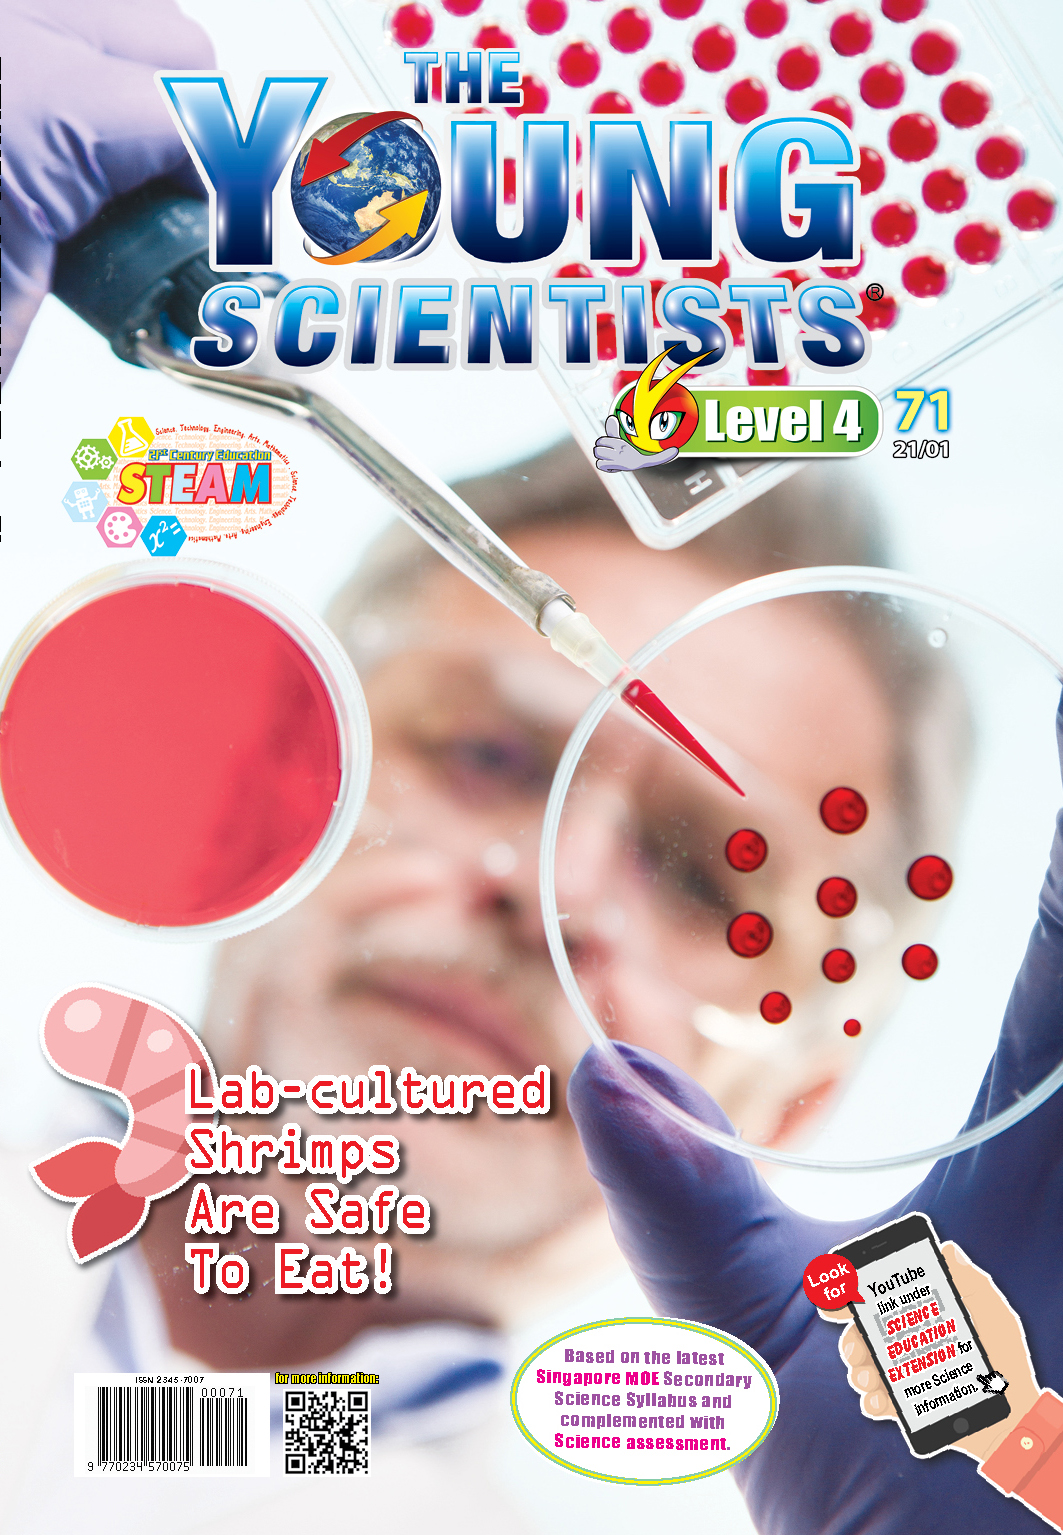
The Young Scientists Level 4- 71 Lab-cultured Shrimps Are Safe To Eat!

Shrimps are small, decapod crustaceans with long elongated bodies, thin, fragile legs and exoskeletons for protecting and giving shape to their bodies. They provide a great source of protein and essential minerals such as iodine that enriches the hormones in the thyroid glands of humans to facilitate body growth and development.
版面:
固定
插圖:
許多